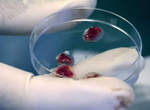

國外選出:噴血不用錢獵奇算剛好的血腥電影 TOP10

圖片來自:tumblr.com
鬼月雖然應該要多分享些恐怖片~不過會令人受不了的畫面其實也不只鬼而已,整個畫面大爆血一樣也會讓你受不了~因此!今天我們就來看看國外選出的十大噴血不用錢獵奇算剛好的血腥電影,首先第一部就是傳說中的力王...這部片之經典就連老外也讚不絕口,當時的主要演員為樊少皇、何家駒等等
注意!每支影片都充滿血~腥畫面
10.力王 Story Of Ricky

圖片來自:trash66.nnm.ru
9.北斗神拳
基本上雖然不是真人電影呈現,但是小兵被打到爆炸在動畫裡也是經典場面~血腥度絲毫不遜色其他真人電影

圖片來自:http://face1.blog90.fc2.com/blog-date-200902.html原汁原味的內容在這裡
8.掃描者 Scanners

圖片來自:http://simplydead.blog66.fc2.com/blog-entry-271.html
注意!每支影片都充滿血~腥畫面
7.吸血鬼大戰科學怪人
這部片雖然出血量高~但是女主角川村由紀惠以及那個女科學怪人都太養眼了說

圖片來自:jffh.de
6.東京残酷警察

圖片來自:jffh.de
5.刀鋒戰士
據說刀鋒常常作夢...每次都夢到有一對情侶躺在草原的中間,每正當衝過去要殺它的痛快時...那場夢就會醒,所以刀鋒每次都會說...e04!就差這麼一點

圖片來自:moviefone.com
注意!每支影片都充滿血~腥畫面
4.機關槍少女
如果常常看這類型日本噴血片的朋友應該都很清楚~這類型的片子沒在計較那幾家崙的血噴出><

圖片來自:http://gentosya.blog74.fc2.com/blog-entry-775.html
注意!每支影片都充滿血~腥畫面
3.THE TOXIC AVENGER

圖片來自:moritalala.jugem.jp
2.第九禁區
大蝦堪稱09年最屌的片子之一,這部片之特殊讓我到現在都還難以忘懷

圖片來自:http://blog.goo.ne.jp/hiralyn/e/92212abf41e42585930341540ddf6046
注意!每支影片都充滿血~腥畫面
老外認為最經典的噴血片是...
1.空房禁地
這片在各方面的爽度都逼近一種極限、極致...簡直就是一種藝術了!我不會說啦~底下影片看了就知道

圖片來自:mondo-gore.com
以上就是國外選出的10大噴血不用錢影片
大家有沒有喜歡的作品也在榜上呢
不過說到阿漆的最愛
還是空房禁地啦~
部分資料來自網路 ( io9 )

0 則回應
順序: 新│舊